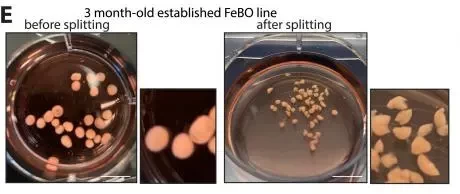

科学家对人脑发育的探索从未停止。近日由类器官领域先驱Hans Clevers及马克西马公主儿科肿瘤学中心、Hubrecht研究所共同组成的科研团队,首次利用人类胎儿大脑组织成功衍生出在体外自组织生成的大脑类器官(FeBO)。相关研究成果在顶级学术刊物《Cell》(影响因子 IF =64.5)发表,该试验实现了类器官技术在大脑研究领域的“里程碑”式重大发展,为深入研究大脑发育,探索大脑发育障碍、脑肿瘤等大脑发育相关疾病开辟了新路径。
大脑是人体的核心器官之一,是重要的神经中枢,负责支配和控制人类的一切生命活动。目前已知,在婴儿出生时大脑已经有许多神经元,然而科学家很难直接在人类身上研究大脑早期在子宫内的发育情况。
尽管此前已有一些动物模型实验的尝试,但人类与动物(小鼠等)大脑发育存在显著差异。如何在实验室内培养可以研究人类大脑早期发育的体外模型,成为困扰科学家的难题之一。
近日,由荷兰马克西马公主儿科肿瘤学中心和Hubrecht研究所领导的科研团队,成功在培养皿中培养出人类胎儿脑组织的3D微型大脑类器官,为研究大脑发育提供了新方法,有助于科学家深入研究大脑发育障碍、脑肿瘤等大脑发育相关疾病。

△ 该研究由乌特勒支Hubrecht研究所的Hans Clevers教授与荷兰马克西马公主儿科肿瘤学中心的干细胞生物学家Benedetta Artegiani等人联合发起,成功利用人胎大脑组织生成类器官(FeBO),研究成果荣登顶级期刊《Cell》,成为2024开年以来类器官研究的重磅新闻。
01
首次用人胎脑组织生成类器官
推进人脑研究“里程碑”式发展
科学研究从来不是一蹴而就的,对于类器官这个全新的研究领域更是如此。
科学家们一直尝试用不同的方法来模拟健康组织或疾病的体外模型,包括早期的2D细胞系,动物实验,以及最近的3D类器官微型模型等。随着类器官技术的不断进步,促使科学家在实验室中模拟器官功能的特征及组织复杂程度的“梦想”成为可能。
2007年,马克西马公主儿科肿瘤学中心(Princess Máxima Center for Pediatric Oncology)的干细胞生物学家Benedetta Artegiani博士(也是本次大脑类器官实验的发起人之一)曾与同事们报告了题为“人类胎儿大脑自组织成长期扩展的类器官”的研究论文,试图打破现阶段只有多能干细胞衍生大脑类器官的现实。
时隔多年,Artegiani博士与Hubrecht研究所Hans Clevers教授等人一起,首次实现了利用人类胎儿大脑组织直接衍生人脑类器官的创举!
他们惊讶地发现使用小块胎儿脑组织(来自皮层、前脑和脊髓等不同大脑区域),而非原始组织分解的单细胞,竟然在体外自主生成大脑类器官(FeBOs)。

△ 一个完整的人类胎儿大脑器官的图像。干细胞用SOX2(灰色)标记,神经元细胞(TUJ1)根据深度用从粉红色到黄色的颜色编码。
这个大脑类器官大约有米粒大小,展示出一个复杂的3D结构,其中包括许多不同类型的脑细胞。重要的是,还包含许多所谓的外侧放射胶质细胞(outer radial glia)——一种在人类和我们的进化祖先中发现的细胞类型。这强调了该大脑类器官与人类大脑的相似性以及在研究中的用途。
这些胎儿脑组织还产生了构成细胞外基质(ECM)的蛋白质,被认为是细胞周围的一种“支架”。科学家认为,这些蛋白质或许是大脑组织碎片能够自我组织生成3D大脑结构的重要原因。
他们还发现,这样生成的大脑类器官保留了它们来源的大脑特定区域的各种特征(可以对大脑发育中起到重要作用的信号分子做出反应)。这将有助于进一步研究脑细胞的环境,探究大脑是如何发育和分化的,有望解开这些细胞外基质如何在指导大脑发育的复杂分子网络中发挥作用的谜题。

△论文图形摘要。该研究将有助于对大脑发育的深入研究,提供脑肿瘤、大脑发育相关疾病的治疗新路径。
鉴于组织衍生的大脑类器官(FeBO)具有快速扩张的能力,科学家们还研究了它们在模拟脑肿瘤中的潜力。利用CRISPR-Cas9“基因魔剪”技术在FeBO的少数细胞中引入了众所周知的癌症基因——TP53的错误。
3个月后,TP53基因缺陷的细胞已经完全取代了类器官里的健康细胞,这意味着它们获得了生长优势,这是癌细胞的典型特征。
△多组大脑类器官在培养皿中裂解过程的代表性图像。
这个类器官模型将有助于科学家测试新的脑癌治疗药物。他们还计划使用胎儿脑类器官来研究唐氏综合征等神经发育障碍疾病。
为了进一步研究脑肿瘤与基因突变的关系,科学家使用CRISPR-Cas9技术关闭了与脑胶质母细胞瘤(Glioblastoma,胶质母细胞瘤是星形细胞肿瘤中恶性程度最高的胶质瘤)相关的三个基因:TP53、PTEN和NF1。经由基因突变的类器官可以观察它们对现有肿瘤药物的反应。
通过CRISPR-Cas9基因编辑技术,科学家在实验中实现了用于脑肿瘤研究的基因突变大脑类器官模型,FeBO构成了一个互补的中枢神经系统类器官平台。并且在肿瘤药物研究中,具有将某些药物与特定基因突变联系起来的潜力,有望为脑肿瘤患者精准用药和个体化治疗提供新方案。
通过研究,科学家们发现这个大脑类器官具有快速扩张的能力,即增殖能力,可以在培养皿中持续生长超过6个月。更为重要的是,通过增殖可以让它们从一个组织样本中长出许多类似的大脑类器官。

△ 成熟的大脑类器官(扩增2-3个月后成熟)中指示标志物的代表性免疫荧光图像。
此外,带有脑胶质母细胞瘤基因突变的微型肿瘤类器官也可实现增殖,并保持相同的突变组合。这一特性表明,科学家们可以利用这些大脑类器官进行重复实验,以此提高科研结果的可靠性。
Hubrecht研究所的干细胞生物学家Delilah Hendriks表示,到目前为止进行的实验只是“冰山一角”。未来,科学家将进一步探索新的组织衍生大脑类器官的潜力,他们还计划继续与已经参与形成这项研究的生物伦理学家合作,以指导新的大脑类器官的未来发展和应用。
02
日新月异的类器官技术
将颠覆传统大脑研究
这一开创性大脑类器官的诞生,无疑为加速类器官技术发展注入了“助推剂”。不仅令参与研究的科学家们备受鼓舞,而且让更多大脑相关疾病患者感受到科技进步带来的曙光。
加州大学旧金山分校神经学家Arnold Kriegstein表示,研究人员已经为这种新的类器官“展示了一些有趣和创造性的用途”。他认为胎儿脑类器官可以帮助研究人员解决以前未能接触到的问题,比如特定神经元是如何在发育成熟的大脑中分化完成的。

△ 四张不同人类胎儿大脑器官的放大图像。不同的神经标记被染色,描绘了它们的细胞异质性和结构。
马克西马公主儿科肿瘤学中心Benedetta Artegiani指出,尽管这些类器官可以作为研究大脑的替代物,但原始干细胞必须通过引入信号分子的混合物,从而“刺激”干细胞发育到类似大脑的状态。这是一个复杂的过程,可能无法完全复制正常的发育过程。
之前有研究人员已经用人类胎儿肠道、肝脏和肺组织培育出相应的类器官,但没有用胎儿脑组织培育过类脑器官。相比之下,使用天然胎儿脑组织培育类脑器官可能有助于揭示人类大脑的真实发育过程。
“由人胎脑组织衍生的大脑类器官将成为研究人类大脑发育的一种宝贵的新工具。如今,我们可以更为轻松地研究发育中的大脑是如何扩张的,并观察不同细胞类型及其环境的作用。”研究论文共同作者之一Artegiani表示,“这个全新的大脑类器官模型让我们能够更好地了解发育中的大脑如何调节细胞的身份。它还有助于了解这一过程中的错误如何导致小头畸形等神经发育疾病,以及其他可能源于发育失常的疾病(比如儿童脑癌,唐氏综合征等)。”
马克西马公主儿科肿瘤学中心的附属小组负责人Delilah Hendriks博士表示,“组织衍生的大脑类器官将是大脑类器官领域的重要补充,科学家可以通过这两个不同的模型,解码人类大脑的复杂性。”
对此,类器官研究的先驱,也是本研究的主要发起人之一Hans Clevers博士教授说道,“自从我们在2011年开发出第一个人类肠道类器官以来,很高兴看到了这项技术的真正起飞。从那以后,人体几乎所有的组织都可以衍生出类器官,包括健康的和患病的(甚至还有越来越多的儿童肿瘤)”。
Hans Clevers表示,到目前为止,我们已经能从大多数人体器官中培养出微型类器官,尤其是大脑这个难以逾越的“鸿沟”,也实现了技术突破,这真的很令人兴奋!”
综上,类器官技术虽然只有短短的十几年,然而在技术创新方面却是一路“高歌猛进”式的。随着类器官作为人体组织和器官体外研究平台的日益精进,人类将颠覆过往医学研究的重重阻碍,实现疾病模型、精准医疗、基因编辑等各领域研究成果的“繁花”盛放。
写在最后
飞速发展的类器官技术同样也面临传统医学前所未有的“伦理”问题。尽管人胎大脑类器官研究实属类器官研究,尤其是大脑类器官研究过程中的重大突破,然而研究团队使用的从堕胎中获得的胎儿组织仍存在伦理争议。对于大多数科学家来说,多能干细胞衍生的类器官可能更容益获得并进行研究,从组织直接衍生类器官的研究仍是长路漫漫。



